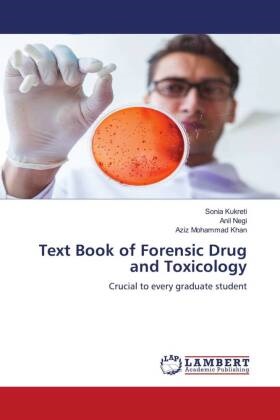

Description
Product details
| Authors | Sonia Kukreti, Aziz Mohammad Khan, Anil Negi |
| Publisher | LAP Lambert Academic Publishing |
| Languages | English |
| Product format | Paperback / Softback |
| Released | 10.10.2024 |
| EAN | 9786208170240 |
| ISBN | 9786208170240 |
| No. of pages | 60 |
| Subject |
Natural sciences, medicine, IT, technology
> Medicine
> General
|
Customer reviews
No reviews have been written for this item yet. Write the first review and be helpful to other users when they decide on a purchase.
Write a review
Thumbs up or thumbs down? Write your own review.